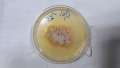
أعراضه تشبه الإنفلونزا.. رصد أول...

الأردن.. أذان المغرب يرفع في كنيسة استضافت إفطارا لأيتام
رُفع أذان المغرب في كنيسة بمدينة السلط الأردنية، الخميس، حيث أقيم إفطار رمضاني لعشرات الأطفال الأيتام. ووفق مراسل الأناضول، نظمت الإفطار جمعيات محلية مختلفة في قاعة كنيسة دير اللاتين. وعلى هامش الإفطار، قالت رايه خليفات، إحدى المشاركات في التنظيم: "هذه الفعالية تقام للعام الثاني، ونستهدف من خلالها نحو 200 طفل من الأيتام وأطفال الملاجئ وعمال وطن". وبيّنت خليفات للأناضول، أن "مدينة السلط، كما هو الحال في سائر المملكة، منذ قديم الزمان تتميز بروح الألفة والمحبة بين كافة أطيافها، مسلمين ومسيحيين". وتابعت: "لذلك وكما ترى، الإفطار والأذان من داخل قاعة الكنيسة، وسنكرر هذه الفعالية ثلاث مرات خلال شهر رمضان المبارك". من جهته، أشار ميشيل فشحو، رئيس جمعية "المحبة والرحمة"، إحدى الجهات المنظمة، للأناضول: "أردنا من خلال هذه الفعالية تأكيد رسالة المحبة والسلام وعمق العلاقة المتواصلة في المجتمع المحلي، مسلمين ومسيحيين". وتقع مدينة السلط على بعد 30 كم غرب العاصمة عمان، وهي رابع أكبر مدن المملكة سكانًا، وسميت قديمًا بـ"سالتوس" نسبة إلى القائد اليوناني الذي فتحها زمن الإسكندر المقدوني وبنى فيها معبدا لـ "الإله زيوس" بمنطقة "زي". وعام 2021، وافقت لجنة التراث العالمي التابعة لمنظمة الأمم المتحدة للتربية والعلوم والثقافة "يونسكو"، على إدراج السلط "مدينة التسامح والضيافة الحضرية" في قائمة التراث العالمي.